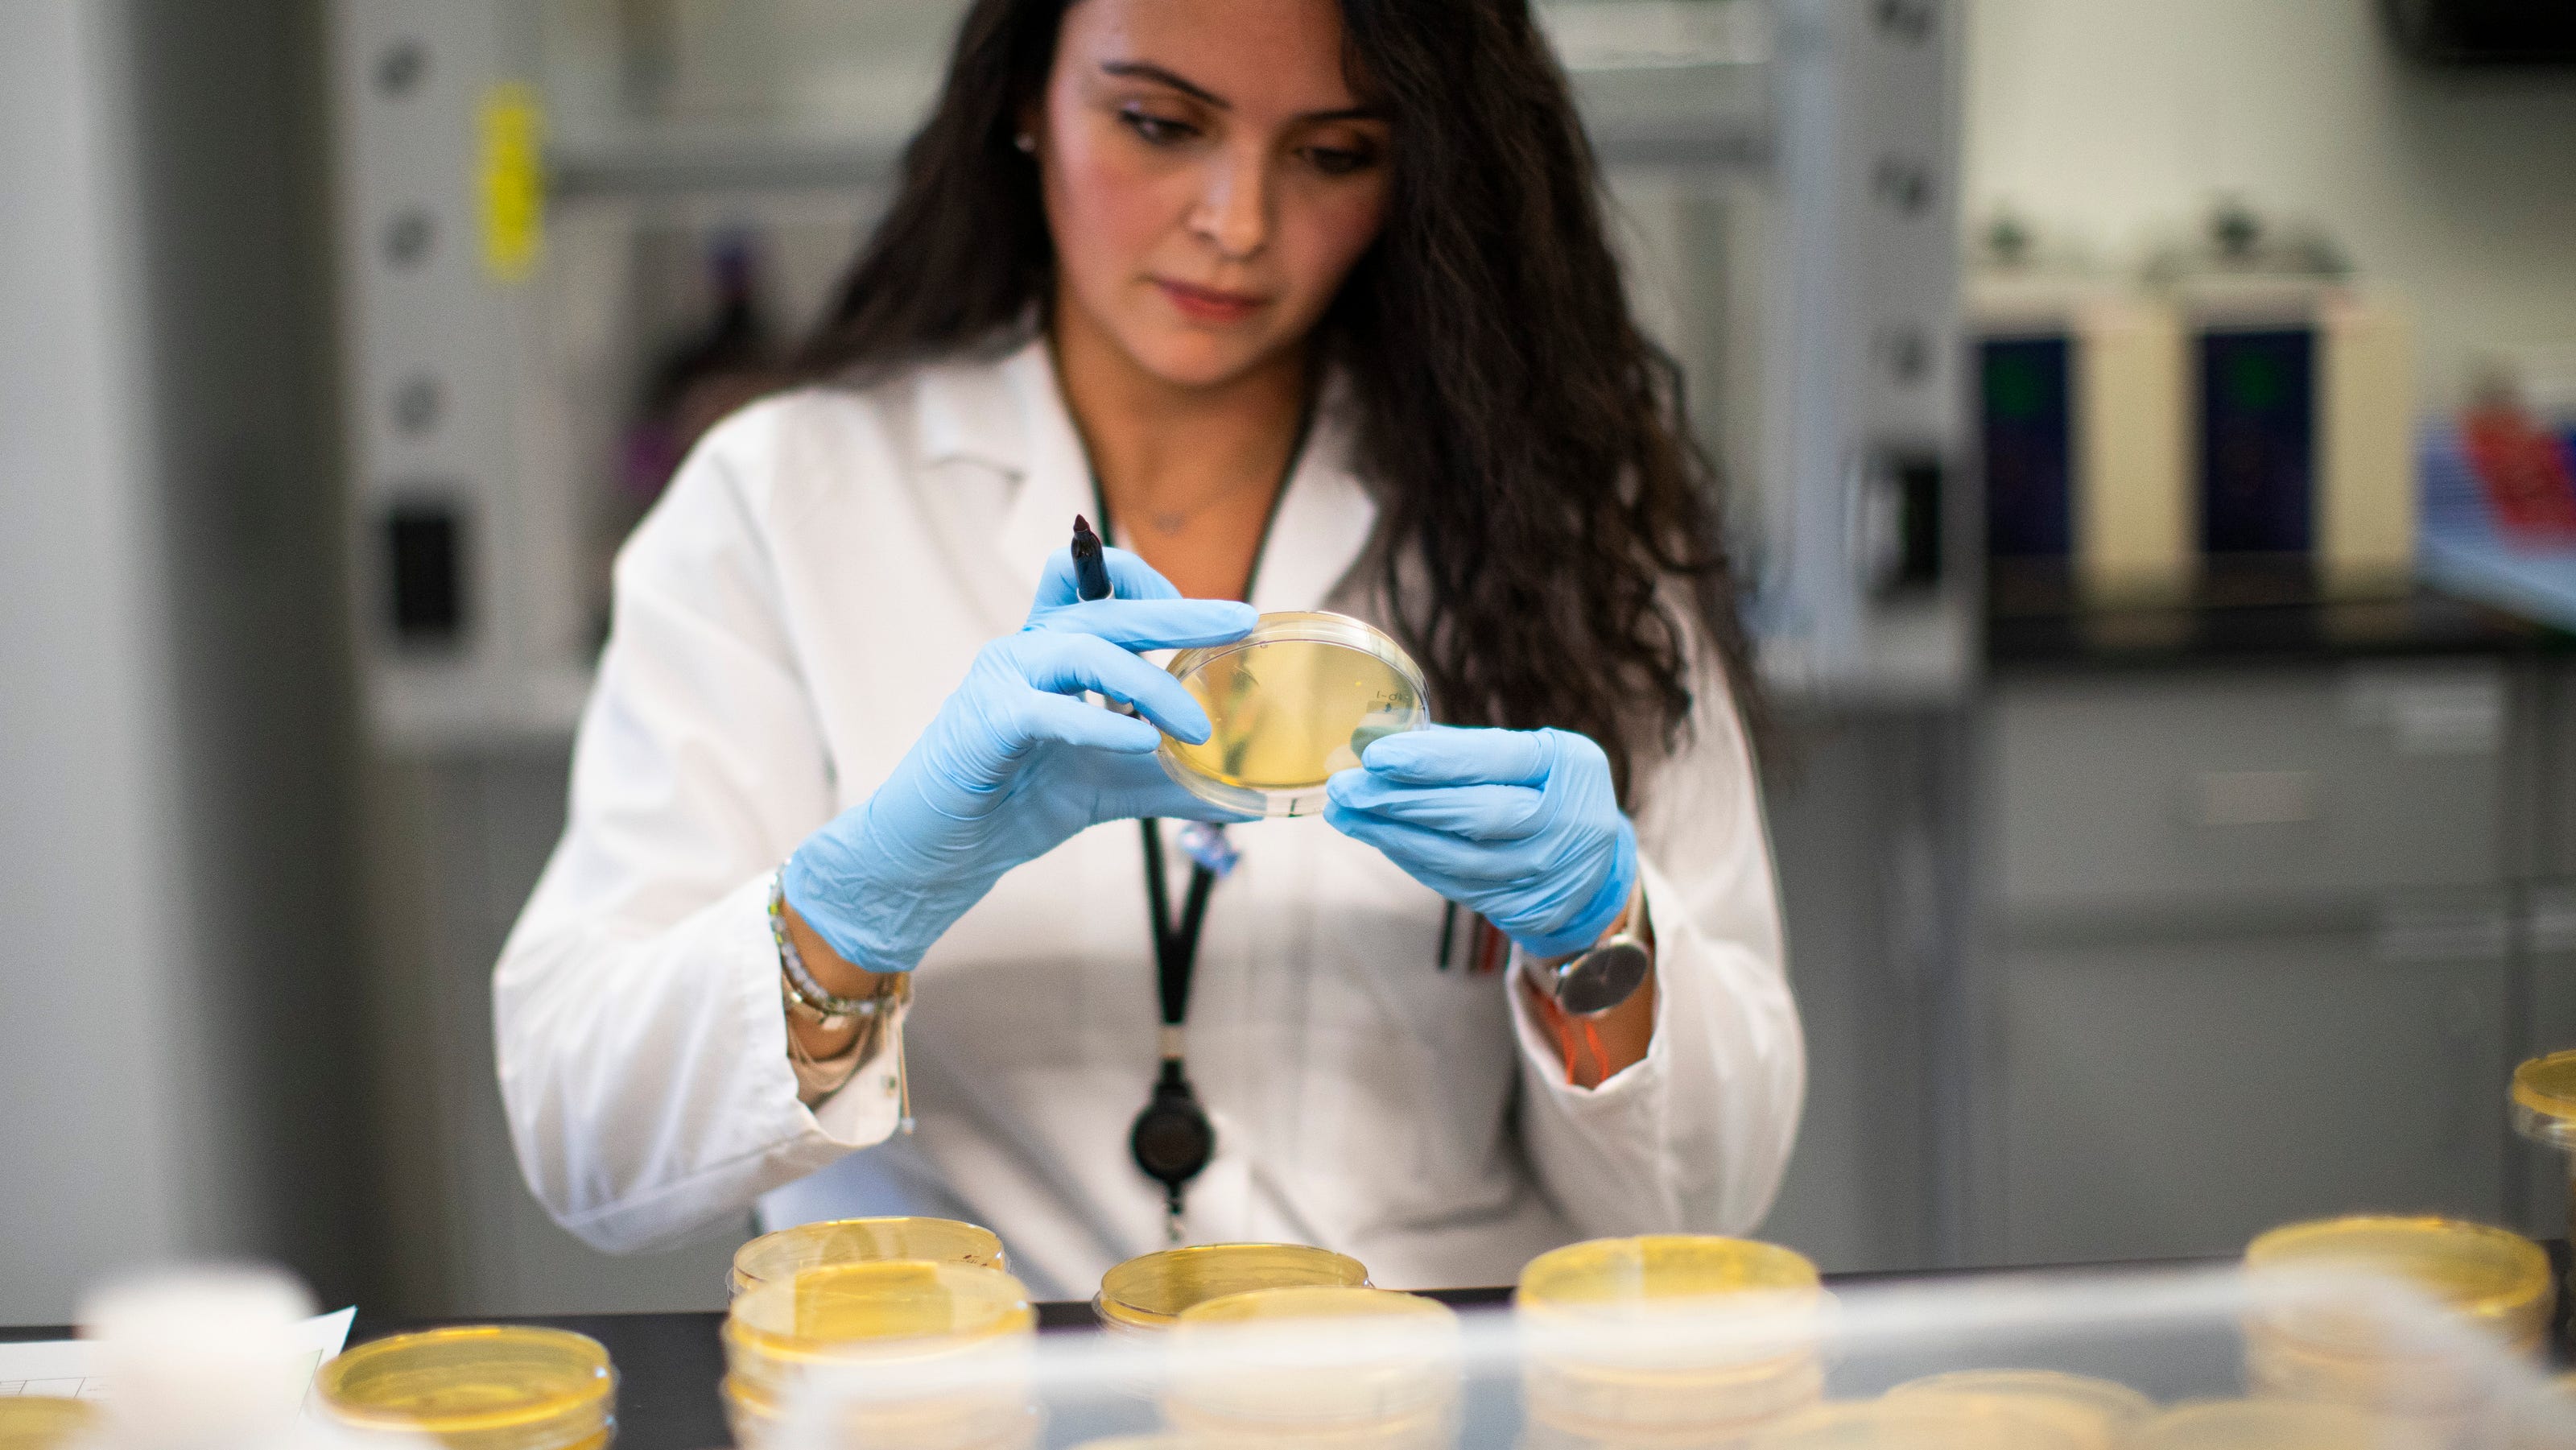

North Jersey to become hub of COVID drug development with $108M grant

Major research institutions led by scientists at Hackensack Meridian Health’s laboratory in Nutley are teaming up to develop new COVID-19 treatments with federal grants up to $108 million as the virus continues to mutate into new forms, executives announced Tuesday.
The partnership among virologists and drug makers aims to rapidly develop drugs that can be taken by mouth without a patient having to be admitted to a hospital. Their goal is to be nimble enough to produce treatments that can respond to a rapidly-changing virus, which can mutate into new variants that only take weeks to spread across the globe.
Dubbed the “Metropolitan AntiViral Drug Accelerator,” the program is being launched at a time when COVID is still spreading rapidly in the U.S. and New Jersey, but physicians are seeing less severe illness, especially among the vaccinated.
Subscribers:What will COVID look like this summer in NJ? Here’s what the latest models show
The initial grants from the National Institutes of Health and the National Institute of Allergy and Infectious Disease total a combined $65 million over three years, which could increase to $108 million if the program is re-upped for two additional years.
The teams that include scientists from Rutgers, Columbia, Rockefeller University in New York, and pharmaceutical maker Merck & Co. will create and test “small-molecule antiviral drugs” to target all kinds of coronaviruses but emphasizing COVID-19. The research produced here could also help with future viral threats, scientists said Tuesday.
Current monoclonal antibody treatments have shown to be effective in keeping severe outcomes at bay. Physicians at Hackensack Meridian and Bergen New Bridge hospitals say they have rarely had to admit COVID patients in recent months and simply send them home with the drugs.
The spring surge is being propelled by subvariants of omicron that have shown to be highly transmissible but less virulent so far.
Most New Jersey hospitals are reporting few serious cases of illness, with fewer than 50 patients on ventilators statewide over the Memorial Day weekend. The daily COVID death toll in New Jersey has been in the single digits for almost three months, following the initial omicron wave in December and January that saw upwards of 80 to 100 deaths each day.
The Metropolitan AntiViral Drug Accelerator scientists will focus on a set of eight molecular features in the virus which play critical roles in replication, maturation, and immune-system evasion.
The teams have already begun working on five projects focusing on the viral targets and matching drugs that would be effective against them.
Other institutions that will be working on the project include Memorial Sloan-Kettering Cancer Center, the nonprofit Tri-Institutional Therapeutics Discovery Institute and Aligos Therapeutics, a California company.
Much of the work will be done at Hackensack Meridian’s Center for Discovery and Innovation, which houses 21 laboratories and more than 150 researchers at its Nutley campus.
This story will be updated.
Scott Fallon has covered the COVID-19 pandemic since its onset in March 2020. To get unlimited access to the latest news about the pandemic’s impact on New Jersey, please subscribe or activate your digital account today.
Email: fallon@northjersey.com
Twitter: @newsfallon /